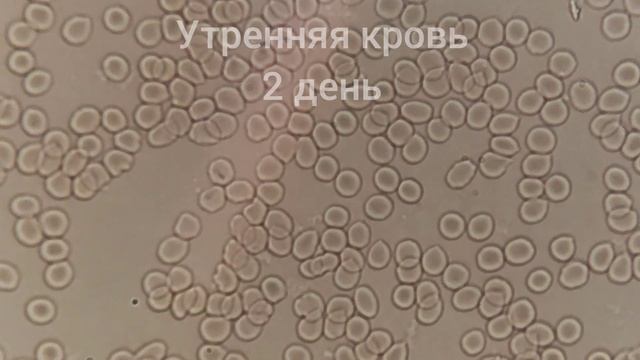
Кровь после 2,5 суточного голодания и очищения кишечника смотреть онлайн

Автор: Уборка и экологическая забота Страница 5

Урок 013 Одинарные теги HTML полный список

Очень вкусная закуска из перца. Маринованный перец быстрого приготовления

Сравнение помытой и не помытой линзы Пассат Б6 Passat B6

удивительно нежные куриные желудки.

Вебинар Романа Попова "Адгезивные технологии"

Женский микс Esmara. Лот 11 (21.6)

Готовим вкуснейший салат на углях?O salata din legume coapte??

Подарок себе на НГ - LG 65UN73506LB

New Plan! Replicator on a Raft! - S5 Ep2 - Official Small Tribes - ARK: Survival Evolved

grade 5 lesson 12 Information for tourists p 92 English plus

Лечим ментальное здоровье ► The White Door | Полное прохождение на русском #1

Как очистить чат в Clash Of Clans
Кровь после 2,5 суточного голодания и очищения кишечника

Как изменить количество и размер иконок в Launchpad на macOS ТОП фишки macOS

Беспроводной вертикальный пылесос для дома Electrolux WELL Q6

Vlog#28: гардероб в ZARA за 30 тыс руб

Возможности КТ диагностики. Биопсия.

Белорусское Женское Белье Интернет Магазин

Toyota Corolla Е150 Как легко и просто почистить климат контроль

Как получить ключи активации windows бесплатно

Как повысить КПД пеллетного котла! Оптимизация горения! Теория и практика!

Tsuniv DZ Мама, я помою посуду 16 05 2015

Создание моей карты в фар край 4

HP Photosmart C6380 All-in-one - printer-scanner-copier
За каждым успешным каналом стоит личность, идея и сотни часов кропотливого труда. Если вы здесь, значит, автор «Уборка и экологическая забота» уже сумел зацепить ваше внимание своим уникальным стилем или подачей. А мы на RUVIDEO позаботились о том, чтобы вы могли изучить весь архив его работ в максимально комфортных условиях — без лишней суеты и преград.
Почему за работами канала «Уборка и экологическая забота» так интересно наблюдать? Всё просто: это честный контент, который находит отклик в сердцах зрителей. На нашем ресурсе вы можете смотреть онлайн все видео любимого автора бесплатно и в хорошем качестве. Нам важно, чтобы вы видели каждую деталь и слышали каждый нюанс, поэтому мы используем только стабильные плееры из открытых источников Rutube.
Следите за новинками канала, пересматривайте старые шедевры и открывайте для себя новые грани творчества «Уборка и экологическая забота». Мы постоянно обновляем ленту, чтобы у вас под рукой всегда были самые свежие выпуски. Никаких сложных регистраций — только вы и творчество, которое вдохновляет. Приятного вам путешествия по миру авторского контента на RUVIDEO!
Видео взято из открытых источников Rutube. Если вы правообладатель, обратитесь к первоисточнику.